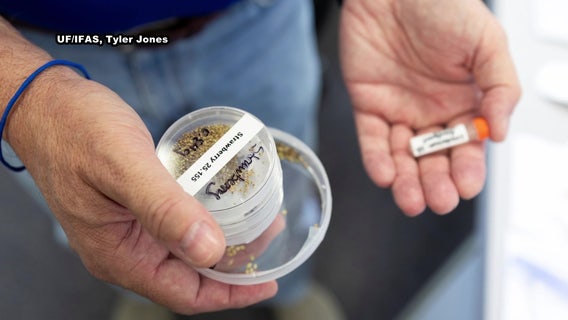
Strawberry seeds from Tampa Bay headed to space in groundbreaking UF experiment

Blue Origin New Glenn Mission NG-2 headed to Mars with NASA's Escapade spacecraft
Blue Origin's New Glen NG-2 Mission successfully launched from Florida's Launch Complex 36 at Cape Canaveral Space Force Station en route to Mars with NASA's Escapade spacecraft.
SpaceX launches 11th test flight of giant Starship
Starship launched from SpaceX’s base in Texas.
SpaceX Crew-11 launches from Florida, headed to ISS: Watch replay
NASA and SpaceX successfully launched the Crew-11 mission from Kennedy Space Center in Florida on Friday, and the spacecraft is now en route to the International Space Station (ISS).
SpaceX, Crew-11 rocket launch scrubbed over weather; now targeting Friday
NASA and SpaceX have delayed Thursday’s planned launch of the Crew-11 mission to the International Space Station (ISS). The mission will mark the next exciting chapter in their partnership to support long-duration human spaceflight and cutting-edge research in low-Earth orbit.
NASA's SpaceX Crew-11 rocket launch from Florida: How to watch, how to stream on Friday
NASA and SpaceX are making final preparations to launch the Crew‑11 mission to the International Space Station on Friday.
Strawberry seeds from Tampa Bay headed to space in groundbreaking UF experiment
On Thursday, researchers from the University of Florida will send thousands of plant seeds, including strawberries grown in Tampa Bay, to space aboard a SpaceX Falcon 9 rocket.
Astronaut photographs elusive luminous event from far above Earth
An astronaut aboard the International Space Station has shared a striking photo of what is known as a Transient Luminous Event seen above a thunderstorm over Mexico and the Desert Southwest earlier in the week.
Florida’s Exolith Lab: Building the blueprint for a moon-based future
UCF scientists are leading global research on how to build roads, landing pads, and infrastructure on the moon using simulated lunar soil.
Project Moon Base: Central Florida's role in building a colony on the Moon
At the University of Central Florida’s Exolith Lab, Dr. Phil Metzger and other university researchers have developed a realistic simulant of moon soil using minerals sourced from across North America.
Mars: Dust Fountains and the Future of Space Colonization
UCF physicist Dr. Ramses Ramirez has a plan to warm Mars using nanotechnology and "dust fountains" to make future colonization more feasible.
NASA, SpaceX, Axiom Mission 4 launches from Florida's Space Coast
NASA, SpaceX and Axiom Space launched Axiom Mission 4 early Wednesday morning following three prior scrubbed launches.
SpaceX Starship spins out after liftoff, falls short of test flight goals
SpaceX launched Starship Tuesday evening, reaching space but failing key mission goals before breaking apart.
Amazon’s Project Kuiper launches first full batch of satellites from Florida
Amazon’s Project Kuiper launched its first full batch of satellites from Florida using a United Launch Alliance (ULA) Atlas V rocket. The rokcet lifted off just after 7 p.m., from Space Launch Complex-41 at Cape Canaveral.
SpaceX launches 28 Starlink satellites into orbit from Florida
SpaceX launched a new batch of Starlink satellites into orbit on Thursday night from Florida.
Lyrid Meteor Shower: When and how to watch in Central Florida
The Lyrid Meteor Shower has been a spectacle for star gazers during the month of April for the past 2,700 years. This meteor shower will reach its peak at the beginning of next week, and we will be able to see it here in Central Florida.
Is Martian dust dangerous? New study reveals long-term health risks for astronauts
New research from the University of Colorado Boulder reveals how breathing in Martian dust could lead to serious health problems for astronauts, from lung damage to thyroid disease.
SpaceX Fram2 Mission: Historic launch of first human flight over Earth’s polar regions
SpaceX successfully launched another historic mission — this time, the Fram2, which will be the first human spaceflight to the Earth’s polar regions.
Space and defense satellite company opens operations center in Tampa
One of the largest space and defense satellite companies in the world is expanding in Tampa.
Video: Dolphins swim near SpaceX's Dragon capsule with Crew-9 inside, moments after splashdown
A very Florida welcome home for NASA and SpaceX's Crew-9. Some curious dolphins seemingly wanted to give a personal “welcome home" to the Crew-9 astronauts, moments after they splashed down off the coast of Florida on Tuesday afternoon.
Crew-9 splashdown in Gulf of America: Astronauts Suni Williams, Butch Wilmore back on Earth
NASA astronauts Suni Williams and Butch Wilmore are back on Earth. NASA and SpaceX's Crew-9 mission successfully splashed down into the Gulf of America, off the Florida Coast on Tuesday evening. It comes nearly 10 months after Williams and Wilmore launched to the International Space Station aboard Boeing's Starliner spacecraft.